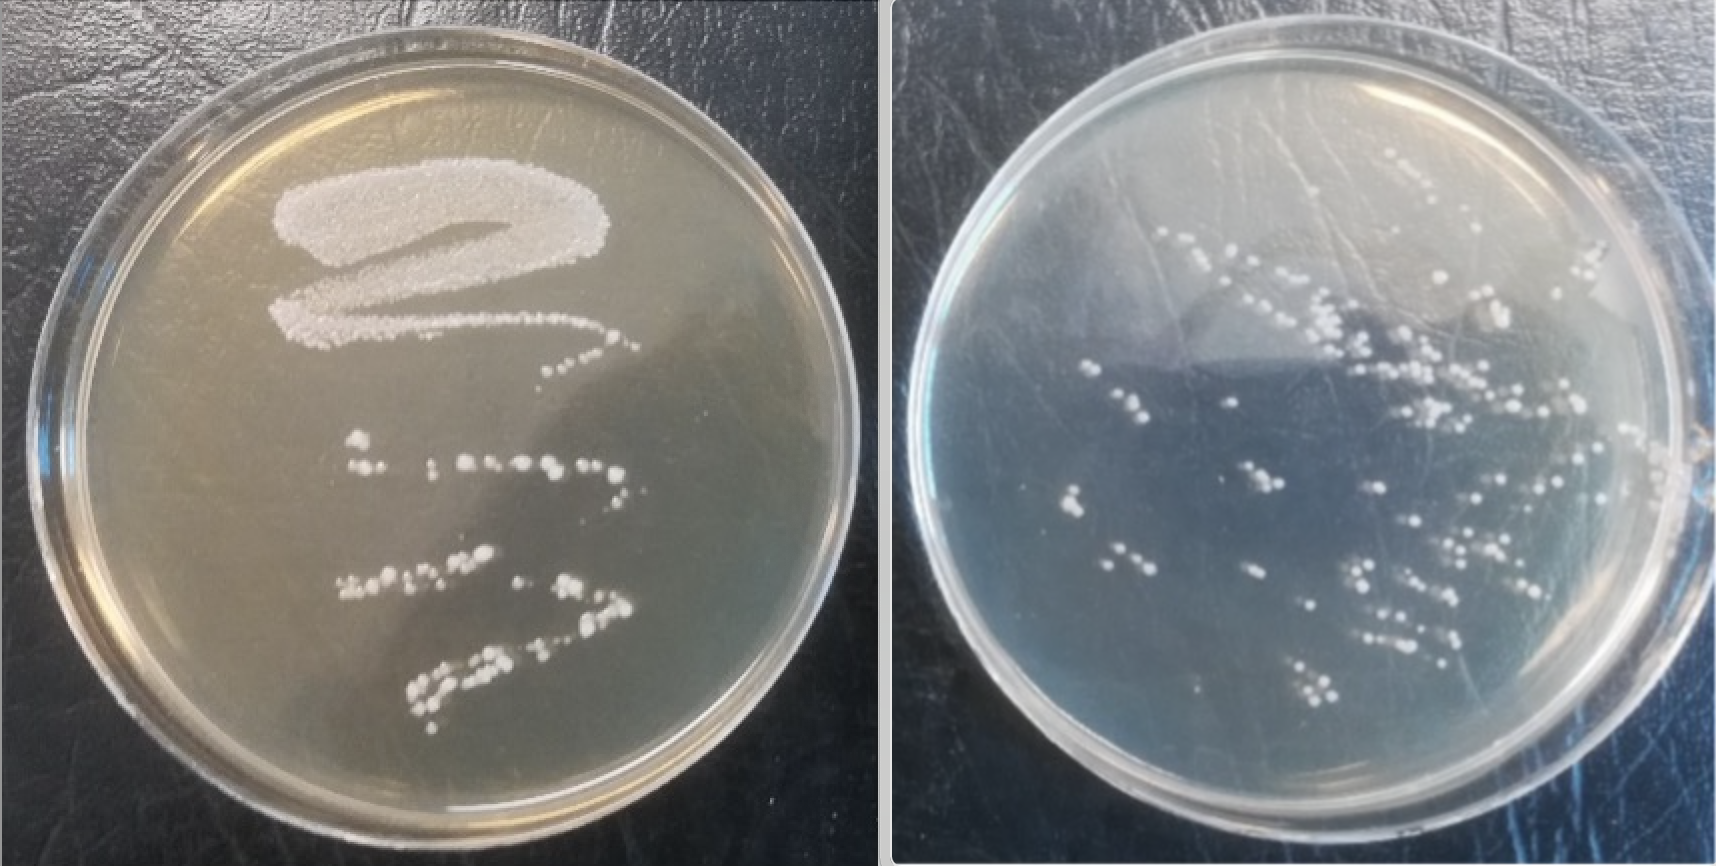
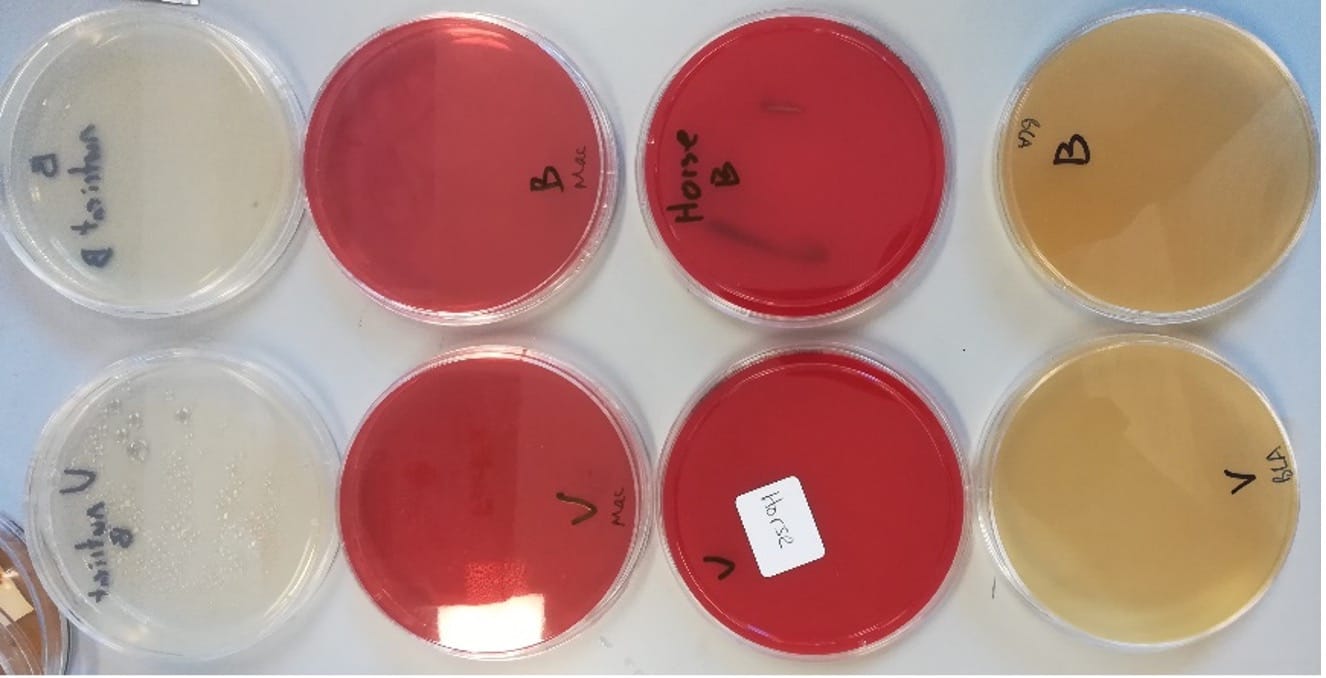

Table of Contents

Comparison between a domestic and international fermented lactobacillus beverage
Craig R. Bunt, Lincoln University, New Zealand
19 June 2020
Summary
The viable bacteria content of LiveBrew and Vita Biosa, two commercially available probiotic supplements were assessed. While LiveBrew viable bacteria content was in agreement with label claims Vita Biosa contained very low levels of viable bacteria well below the label claim. Significant quality differences of each product supports a conclusion that only LiveBrew meets an acceptable definition of what can be claimed as a probiotic.
Introduction
The quality (viable bacteria content) of probiotic supplements such as capsules and tables for human consumption are typically in agreement with label claims (1). These products are based on freeze dried bacteria, their relatively dry nature helps to support the maintenance of viable bacteria in a suspended state. The quality of liquid based probiotic products for veterinary applications on the other hand have been found to vary widely with few meeting label claims (2). The viability of liquid probiotic products is likely to be challenging and with this in mind commercially available products should be tested to assess the accuracy of label claims.
Materials and Methods
A copy of an analytical report of the viable bacteria content of two commercially available liquid probiotic products (Vita Biosa and LiveBrew) conducted by Hills Laboratories (a commercial testing lab) was supplied by BioBrew Ltd.
Vita Biosa was purchased from a local retailer while LiveBrew was provided by BioBrew Ltd. Both were delivered to Lincoln University by a representative of BioBrew and stored as per directions on their packaging.
Peptone for serial dilutions and De Man, Rogosa and Sharpe agar (MRSa) for plate counting were purchased from Thermo Scientific N and prepared as per included directions. Nutrient agar, blood agar, horse blood agar, and brillience listeria agar were supplied by Ara Institute of Canterbury.
LiveBrew and Vita Biosa were streaked directly onto plates to confirm viability and safety. Serial dilution of LiveBrew and Vita Biosa were plated onto MRSa to assess colony forming units of each products.
Results and Discussion
LiveBrew streaked on MRSa showed confluent and heavy growth and discrete colonies whereas Vita Biosa showed only discrete colonies (Figure 1).
Figure 1. LiveBrew (left), Vita Biosa (right).
Streaking of LiveBrew or Vita Biosa separately onto nutrient, blood, horse blood or brilliance listeria agars found no colonies indicating both products possess no biohazards and are likely safe to consume (Figure 2).
Figure 2. LiveBrew (top) and Vita Biosa (bottom) streaked on; nutrient agar (left), blood agar (2nd from left), horse blood agar (2nd from right), brillience listeria agar (right).
Colony forming unit contents of Vita Biosa assessed by Hills Laboratories and Lincoln University found numbers less than 2% of the label claim, whereas LiveBrew contained 120 to 200% as per the label claim as assessed by Lincoln University and Hills Laboratory respectively (Table 1).
Table 1. Colony forming units (cfu) for LiveBrew and Vito Biosa as assessed by Hills laboratory and Lincoln University.
| Hills | Lincoln University | |||
| Vita Biosa | LiveBrew | Vita Biosa | LiveBrew | |
| N | 4 | 13 | 1 | 1 |
| Mean pH | 3.2 | 3.6 | ||
| Mean Lacto | 7 x 105 | 2.0 x 107 | 1.02 x 106 | 1.2 x 107 |
| Label Claim | 1.0 x 108 | 1.0 x 107 | 1.0 x 108 | 1.0 x 107 |
| Compliance with label claim minimum | never | always | no | yes |
| Mean as % of Label claim | 0.70% | 200% | 1.02% | 120% |
Culturing of LiveBrew and Vita Biosa on MRSa, various safety assessment media, and colony forming unit assessments have identified clear differences between the two products.
While both are safe for consumption, only LiveBrew meets the label claims for viable cell content and is capable of delivering the recommended daily dose of probiotic bacteria.
Acknowledgements and statement of conflicts of interest
The laboratory analysis conducted at Lincoln University and preparation of this report received no financial support from BioBrew Ltd.
Dr Craig Bunt has conducted collaborative research projects with BioBrew Ltd. on numerous occasions, however no financial support by way of payment for time to conduct research or prepare manuscripts has been received. Materials have been supplied by BioBrew
References
- Olivier, Bunt, Hardy, “The quality of probiotics in New Zealand”, Asia Pacific Critical Care 2008 Congress, (2008)
- Min Min, Bunt, Mason, Bennett, Hussain, “Effect of non-dairy food matrices on the survival of probiotic bacteria during storage”, Microorganisms, 5(3) (2017), DOI:10.3390/microorganisms5030043
Use the discount code BFD15 for a 15% discount on a first purchase of LiveBrew via our store at livebrew.co.nz
